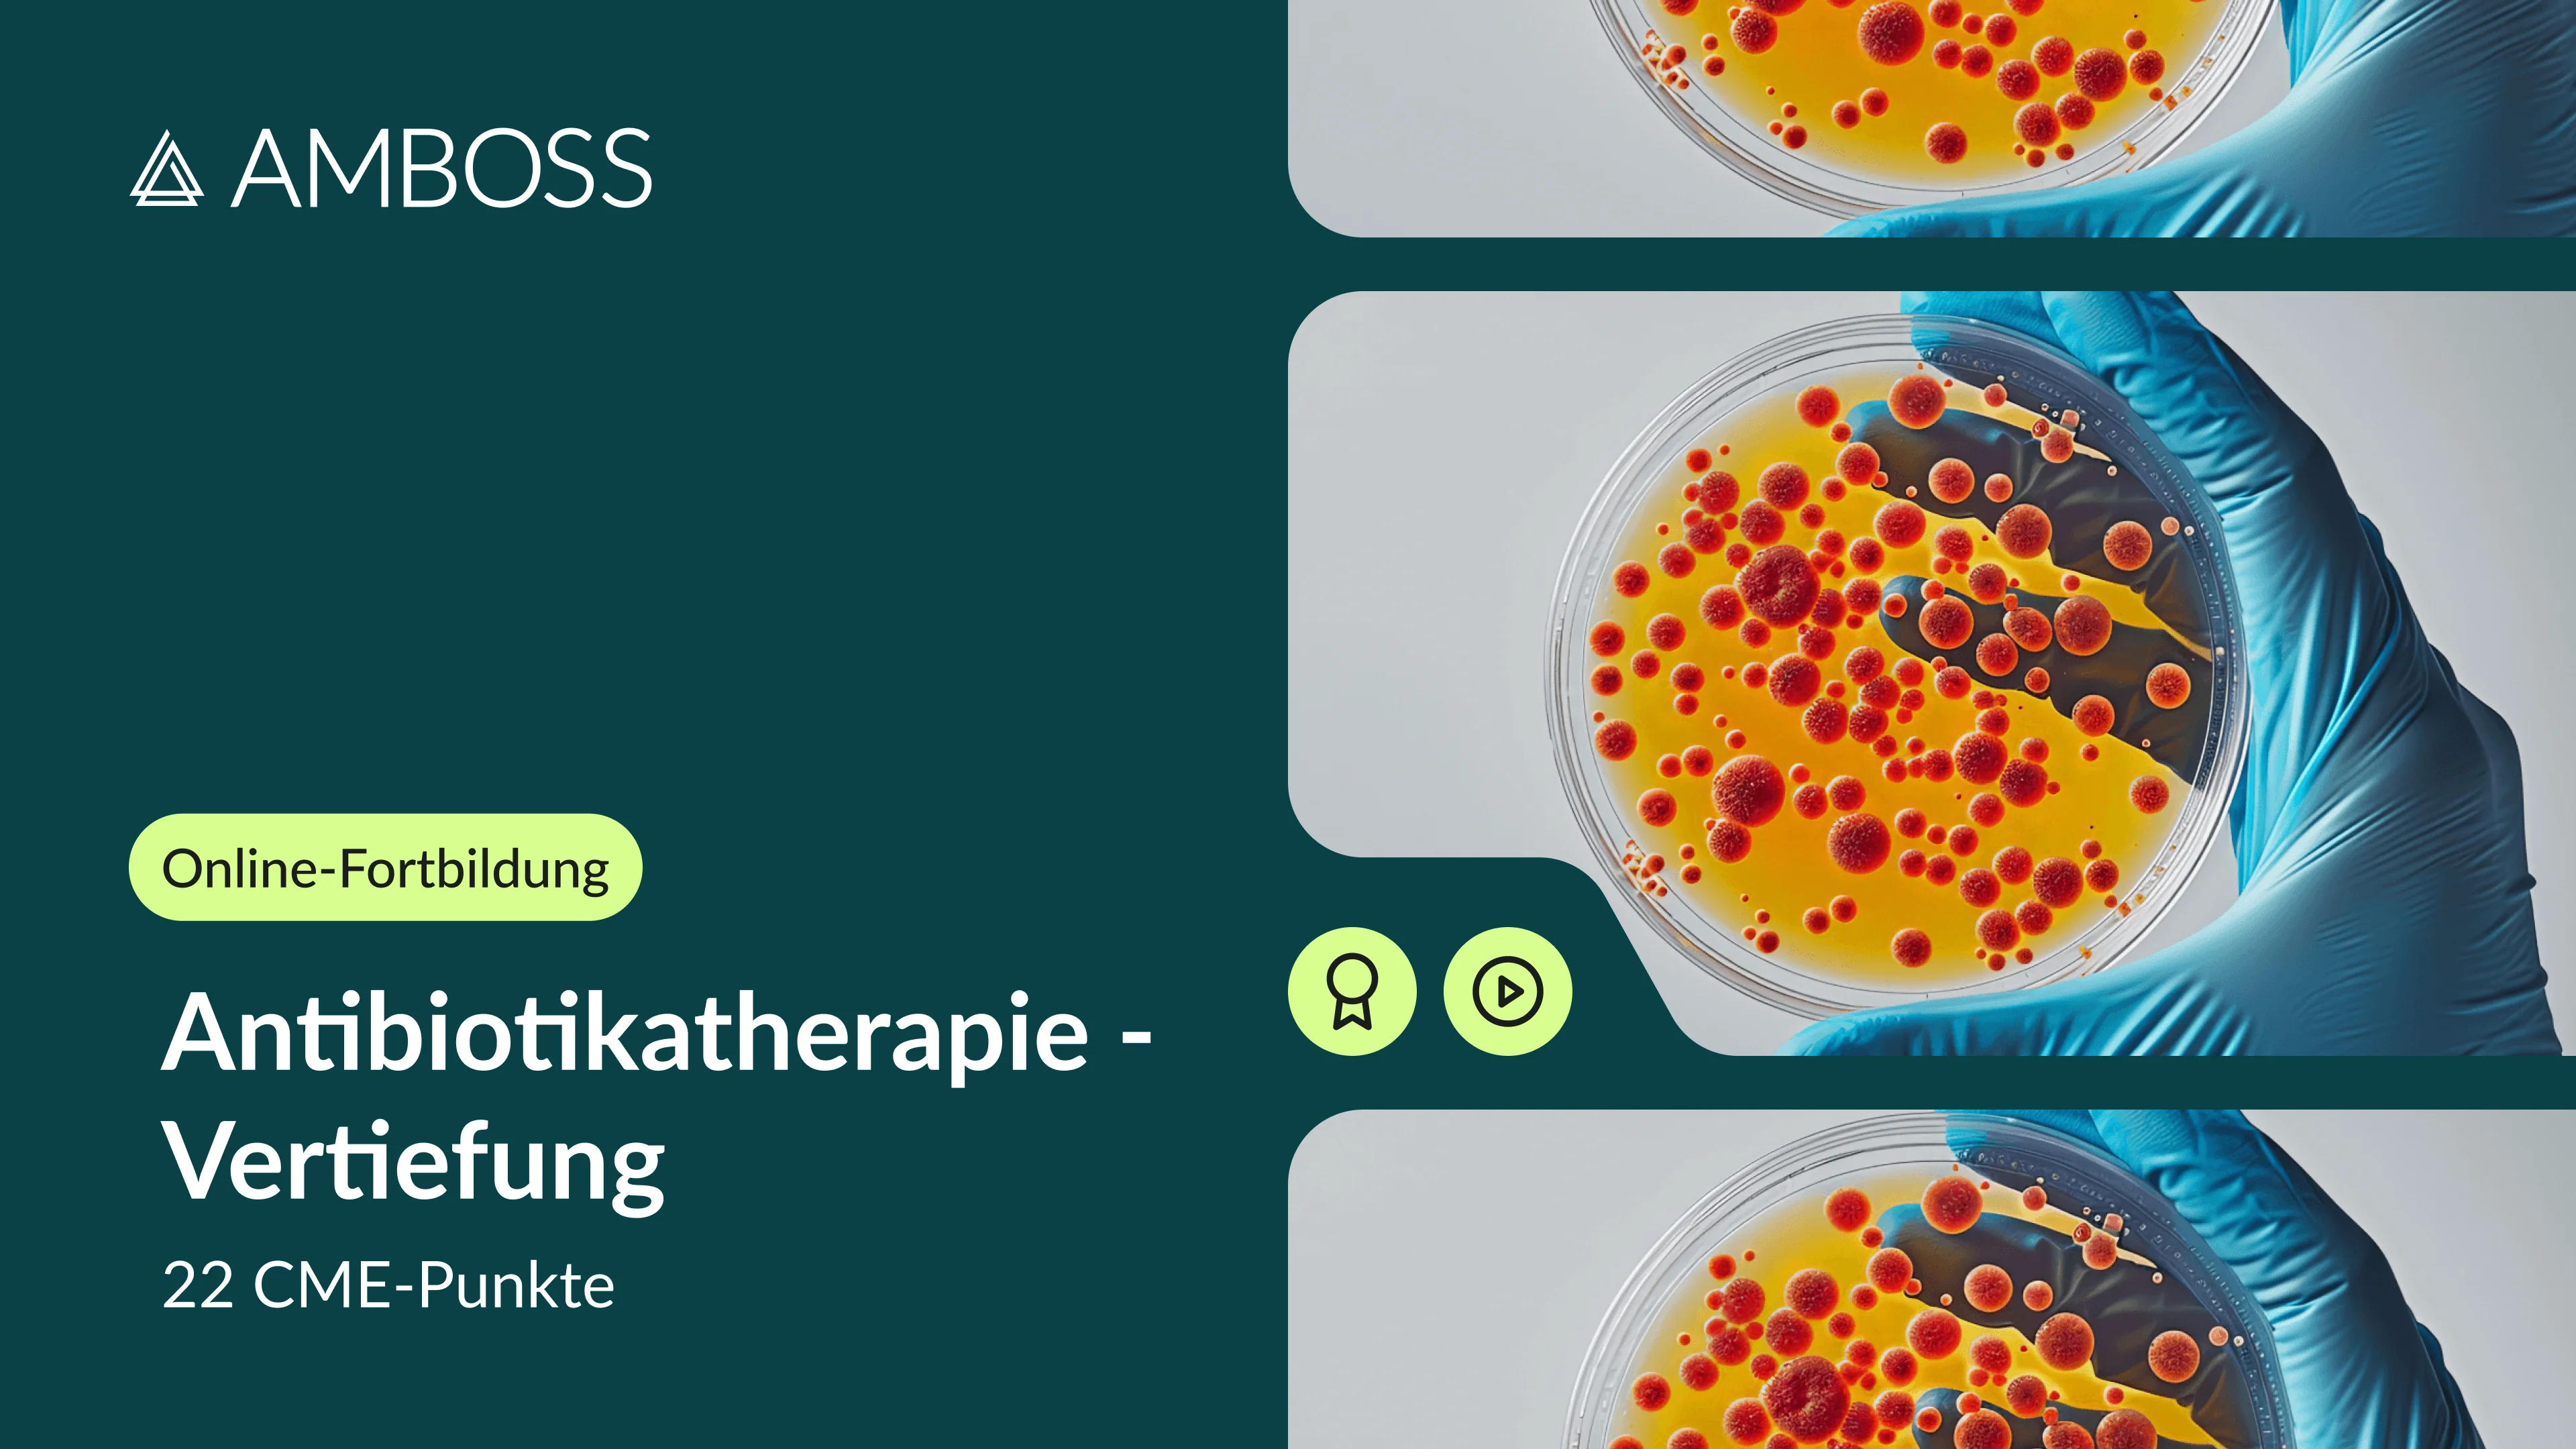

Antibiotikatherapie - Vertiefung
Fortbildungsinhalt
Kursinhalt
In dieser flexiblen Fortbildung erhältst du einen aktuellen Überblick zum Thema “MRE und neue Antibiotika”.
Unsere beiden Experten Prof. Timo Brandenburger und Prof. Detlef Kindgen-Milles erklären dir in insgesamt neun Videolektionen u.a. die Grundlagen zu den Themen multiresistente Keime und neue Antibiotika – fallbasiert und interaktiv mit Quiz-Fragen zum Mitdenken.
Nach dieser Fortbildung behandelst du multiresistente bakterielle Infektionen und invasive Mykosen noch sicherer und verbesserst so die Versorgung auf deiner Station nachhaltig.Die flexible Online-Fortbildung kann jederzeit im Selbststudium absolviert werden.
Themen
- Themen der Bakteriologie
- Resistenzentwicklung
- Nosokomiale Infektionen
- Antibiotikatherapie multiresistenter Erreger
- Pilzinfektionen sowie Antimykotika
Im Paket enthaltene Kurse
Fakten zur Online-Fortbildung
Fakten zum Online-Kurs
„
Antibiotikatherapie - Vertiefung
“
Die Online-Fortbildungen stehen allen Interessierten offen, unabhängig davon, ob sie über einen aktiven AMBOSS-Zugang (z. B. Einzel-Abo oder Kliniklizenz) verfügen.
Ohne aktiven AMBOSS-Zugang wird ein einmaliger Aufschlag für die zeitlich begrenzte Nutzung der AMBOSS-Plattform fällig.
Expert:in
Expert:innen
Häufig gestellte Fragen zum Kurs
Häufig gestellte Fragen zur Fortbildung
Nutzer:innen, die über einen aktiven AMBOSS-Zugang (z.B. Einzel-Abo oder Kliniklizenz) verfügen, können auf den Online-Kurs zugreifen, solange ihr AMBOSS-Zugang aktiv ist.
Der Online-Kurs ist grundsätzlich für einen Zeitraum von zwei Monaten konzipiert.
Darüber hinaus besteht wie oben genannt die Möglichkeit weiterhin auf den Online-Kurs zuzugreifen, solange der AMBOSS-Zugang aktiv ist.
Nutzer:innen ohne aktiven AMBOSS-Zugang (z.B. Einzel-Abo oder Kliniklizenz) erhalten durch den Kauf des Online-Kurses einen zweimonatigen Zugriff auf die Fortbildung (inklusive Zugriff auf die AMBOSS-Wissensplattform).
Danach besteht die Möglichkeit, einen AMBOSS-Zugang zu erwerben, wodurch auch der Zugriff auf den Online-Kurs entsprechend verlängert wird, solange der AMBOSS-Zugang aktiv ist.
Nutzer:innen ohne aktiven AMBOSS-Zugang (z.B. Einzel-Abo oder Kliniklizenz) erhalten durch den Kauf der Online-Fortbildung einen zweimonatigen Zugriff auf die Fortbildung (inklusive Zugriff auf die AMBOSS-Wissensplattform).
Danach besteht die Möglichkeit, einen AMBOSS-Zugang zu erwerben, wodurch auch der Zugriff auf die Online-Fortbildung entsprechend verlängert wird, solange der AMBOSS-Zugang aktiv ist.
Nutzer:innen, die über einen aktiven AMBOSS-Zugang (z.B. Einzel-Abo oder Kliniklizenz) verfügen, können auf die Online-Fortbildung zugreifen, solange ihr AMBOSS-Zugang aktiv ist
Die Online-Fortbildung ist grundsätzlich für einen Zeitraum von zwei Monaten konzipiert.
Darüber hinaus besteht wie oben genannt die Möglichkeit weiterhin auf die Online-Fortbildung zuzugreifen, solange der AMBOSS-Zugang aktiv ist.
Unsere Online-Fortbildungen sind so konzipiert, dass sie auch neben dem ärztlichen Alltag innerhalb von zwei Monaten absolviert werden können.
Der Zugriff auf die Kursinhalte besteht auch nach dieser Zeit, solange ein aktiver AMBOSS-Zugang (z.B. Einzel-Abo oder Kliniklizenz) vorhanden ist, um Kursinhalte zu wiederholen oder Inhalte nachzuschlagen.
Diese Fortbildung wurde frei von finanziellen Interessenkonflikten und Sponsoring erstellt und ausschließlich durch die AMBOSS SE ermöglicht. Das Konzeptionsteam der AMBOSS-Online-Fortbildung Antibiotikatherapie - Vertiefung besteht aus:
Prof. Dr. med. Detlef Kindgen-Milles
- Forschungsförderung Fresenius Medical Care, Infectopharm, Diamed
- Vortragstätigkeit: Biotest, Cardiotours, Cytosorbents, Diamed, Fresenius Medical Care, Infectopharm, med update, Orion Pharma
- Beratertätigkeit: Fresenius Medical Care, Diamed, MSD
Prof. Dr. med. Timo Brandenburger
- Deutsche Gesellschaft für Anästhesiologie & Intensivmedizin, Deutsche Interdisziplinäre Vereinigung für Intensiv- und Notfallmedizin, European Society of Intensive Care Medicine & Berufsverband Deutscher Anästhesisten
- Berufliche Stationen u.a. bei Bayer, Biomerieux, Gilead, Fresenius Medical Care, Stadapharm und Grünenthal
Die Online-Fortbildung „Antibiotikatherapie - Vertiefung” ist anerkannt durch die Ärztekammer Nordrhein (bundesweit gültig).
Die Fortbildung wird mit 22 CME-Punkten zertifiziert. Den Teilnehmer:innen werden die CME-Punkte automatisch auf dem jeweils angegebenen Fortbildungspunktekonto gutgeschrieben, nachdem die Online-CME-Fragen erfolgreich (mind. 7 von 10 Fragen korrekt) beantwortet wurden.
Für alle Teilnehmer:innen des Kurses gilt die allgemeine AMBOSS-Datenschutzerklärung.
Für alle Teilnehmer:innen der Fortbildung gilt die allgemeine AMBOSS-Datenschutzerklärung.
Häufig gestellte Fragen zum Kurs
Häufig gestellte Fragen zur Fortbildung
Das Selbststudium wird dir nicht auf AMBOSS direkt bereitgestellt, sondern durch die Fortbildungsakademie medixum des Deutschen Ärzteverlags. Du erreichst medixum über folgenden Link: Selbststudium: Fortbildung Hautkrebs-Screening
Wir schalten dir den Zugang zum Selbststudium auf medixum i.d.R. am Montag nach deinem Kurskauf frei. Du erhältst hierfür zwei E-Mails mit den Betreffen:
- Willkommen auf der Lernplattform von AMBOSS“ - Ein neuer Kurs steht auf der Lernplattform von AMBOSS für Sie bereit“
Der Absender lautet learning.medixum@aerzteverlag.de.
Du erreichst das Selbststudium auf medixum über diesen Link: Selbststudium: Fortbildung Hautkrebs-Screening. Du findest den Link auch in den E-Mails, die du bei Freischaltung der Kursinhalte am Montag erhalten hast. Um darauf zugreifen zu können, ist ein Account beim Deutschen Ärzteverlag (“Mein DÄ”) notwendig.
Schaue hier, was auf dich zutrifft:
Du hast noch keinen Account beim Deutschen Ärzteverlag? Registriere dich dort bitte mit derselben E-Mail-Adresse, die du auch beim Kauf des Kurses verwendet hast. Du hast bereits einen Account beim Deutschen Ärzteverlag und die dort hinterlegte E-Mail-Adresse stimmt mit jener vom Kurskauf auf AMBOSS überein? Du kannst dich direkt dort einloggen und mit dem Kurs loslegen. Du hast bereits einen Account beim Deutschen Ärzteverlag, aber die dortige Login-Adresse stimmt nicht mit jener vom Kurskauf auf AMBOSS überein? Melde dich bei unserem Support unter hallo@amboss.com. Wir können deine E-Mail-Adresse entsprechend anpassen.
Du kannst dich beim Deutschen Ärzteverlag über die Nutzergruppe „Sonstiger Leser“ registrieren.
Das Selbststudium ist in 9 Module aufgegliedert. Die Themen umfassen u.a. Prävention, spezifische Krankheitsbilder wie Hautkrebs sowie das gesetzliche Hautkrebs-Screening in Deutschland. Sobald du ein Modul erfolgreich abgeschlossen hast, wird das nächste Modul automatisch freigeschaltet. Die Inhalte werden in abwechslungsreichen Formaten wie Videos, Quizzen und Präsentationen bereitgestellt.Das Selbststudium umfasst 4 Unterrichtseinheiten à 45 Minuten, sprich 3 Stunden insgesamt. Am Ende des Selbststudiums steht eine Lernerfolgskontrolle an, in der du dein erworbenes Wissen prüfen kannst. Bitte absolviere das komplette Selbststudium vor dem Live-Termin!
Du hast zwölf Monate lang Zugriff auf die Inhalte des Selbststudiums.
Nein, der Kauf der Fortbildung beinhaltet kein AMBOSS-Abonnement.
Um ein Modul abzuschließen, müssen alle Folien durchlaufen sein. Es kann manchmal passieren, dass ein Modul dennoch nicht als abgeschlossen erkannt wird. Ist das bei dir der Fall, leere bitte deinen Browser-Cache und starte den Browser neu.Sollte das keine Abhilfe schaffen, kontaktiere gerne den Kundenservice von medixum über kundenservice@medixum.de.
Solltest du weitergehende Fragen zum Selbststudium haben, ist der Kundenservice von medixum dein Ansprechpartner. Du erreichst ihn via E-Mail: kundenservice@medixum.de.
Viele Informationen findest du übrigens bereits hier: medixum FAQ.
Auch im Selbststudium auf medixum gibt es links unten am Bildschirmrand eine spezielle Hilfe-Sektion namens „Hilfe FAQ“.
„Das AMBOSS-Support-Team ist wie folgt erreichbar:
Über unser Kontaktformular, WhatsApp oder per E-Mail: hallo@amboss.com- Telefonisch Mo–Fr zwischen 9 und 17 Uhr unter 030 5770 2210.
Bei inhaltlichen Fragen stehen auch die Dozierenden in den Live-Webinaren gerne Rede und Antwort.“
Deine Zugangsdaten zum Live-Webinar senden wir dir direkt mit der Kaufbestätigung per E-Mail zu. Außerdem erhältst du von uns einige Tage vor dem Live-Webinar eine Erinnerungs-E-Mail, damit du alles rechtzeitig parat hast.
Für unser Webinar nutzen wir das Programm Zoom, das du dir hier herunterladen kannst. Es ist allerdings auch kein Problem, wenn du Zoom nicht herunterladen möchtest. Du kannst dann ganz einfach durch Klick auf den Zoom-Link in der E-Mail am Webinar teilnehmen.
In Ausnahmefällen ist es möglich, den Termin deines Live-Webinars zu wechseln. Bitte kontaktiere uns in solchen Fällen über hallo@amboss.com und wir schauen gemeinsam, was wir für dich tun können.
Ja, du findest die Präsentationen zum Live-Webinar in einem speziellen Download-Portal. Der Zugang zu diesem Download-Portal ist im Buchdeckel des Begleitmaterials hinterlegt. Sobald du das Begleitmaterial also per Post erhalten hast, kannst du dich im Download-Portal anmelden und auf die Präsentationen sowie weitere hilfreiche Ressourcen zugreifen.
Häufig gestellte Fragen zur Fortbildung
Häufig gestellte Fragen zum Kurs
Nutzer:innen, die über einen aktiven AMBOSS-Zugang (z.B. Einzel-Abo oder Kliniklizenz) verfügen, können auf die Online-Fortbildung zugreifen, solange ihr AMBOSS-Zugang aktiv ist
Die Online-Fortbildung ist grundsätzlich für einen Zeitraum von zwei Monaten konzipiert.
Darüber hinaus besteht wie oben genannt die Möglichkeit weiterhin auf die Online-Fortbildung zuzugreifen, solange der AMBOSS-Zugang aktiv ist.
Nutzer:innen ohne aktiven AMBOSS-Zugang (z.B. Einzel-Abo oder Kliniklizenz) erhalten durch den Kauf der Online-Fortbildung einen zweimonatigen Zugriff auf die Fortbildung (inklusive Zugriff auf die AMBOSS-Wissensplattform).
Danach besteht die Möglichkeit, einen AMBOSS-Zugang zu erwerben, wodurch auch der Zugriff auf die Online-Fortbildung entsprechend verlängert wird, solange der AMBOSS-Zugang aktiv ist.
Unsere Online-Fortbildungen sind so konzipiert, dass sie auch neben dem ärztlichen Alltag innerhalb von zwei Monaten absolviert werden können.
Der Zugriff auf die Kursinhalte besteht auch nach dieser Zeit, solange ein aktiver AMBOSS-Zugang (z.B. Einzel-Abo oder Kliniklizenz) vorhanden ist, um Kursinhalte zu wiederholen oder Inhalte nachzuschlagen.
Diese Fortbildung wurde frei von finanziellen Interessenkonflikten und Sponsoring erstellt und ausschließlich durch die AMBOSS SE ermöglicht. Das Konzeptionsteam der AMBOSS-Online-Fortbildung Antibiotikatherapie - Vertiefung besteht aus:
Prof. Dr. med. Detlef Kindgen-Milles
- Forschungsförderung Fresenius Medical Care, Infectopharm, Diamed
- Vortragstätigkeit: Biotest, Cardiotours, Cytosorbents, Diamed, Fresenius Medical Care, Infectopharm, med update, Orion Pharma
- Beratertätigkeit: Fresenius Medical Care, Diamed, MSD
Prof. Dr. med. Timo Brandenburger
- Deutsche Gesellschaft für Anästhesiologie & Intensivmedizin, Deutsche Interdisziplinäre Vereinigung für Intensiv- und Notfallmedizin, European Society of Intensive Care Medicine & Berufsverband Deutscher Anästhesisten
- Berufliche Stationen u.a. bei Bayer, Biomerieux, Gilead, Fresenius Medical Care, Stadapharm und Grünenthal
Die Online-Fortbildung wird mit einem Continuing-Nursing-Development-Zertifikat (CND-Zertifikat) abgeschlossen und ist durch die Registrierungsstelle beruflich Pflegender (RbP) bundesweit für alle Pflegefachpersonen anerkannt.Nach erfolgreichem Abschluss des CND-Prüfungsmoduls erhalten die Teilnehmer:innen ein CND-Fortbildungszertifikat inkl. Angabe der erlangten RbP-Punkte. Erfolgreich ist die Teilnahme dann, wenn mindestens 7 der 10 Fragen korrekt beantwortet wurden. Bei Nicht-Bestehen kann die Prüfung jederzeit wiederholt werden
Nach einem erfolgreichen Abschluss des CND-Prüfungsmoduls wird ein CND-Zertifikat inkl. Angabe der erlangten RbP-Punkte ausgestellt ‒ auch wenn an einigen Stellen im Kurs (lediglich) CME-Punkten gesprochen wird. Hintergrund: Der Kurs wurde zunächst CME- und erst später CND-zertifiziert und registriert. Um diese wichtige Online-Fortbildung schnellstmöglich mit eigenem CND-Zertifikat zur Verfügung stellen zu können, haben wir nicht an jeder Stelle des Inhalts beide Punktekategorien (CND und CME) genannt.
Der erste zweijährige Fortbildungszyklus, in dem alle regulären Mitglieder der Landespflegekammer Rheinland-Pfalz verpflichtend 40 Fortbildungspunkte erwerben müssen, beginnt am 1. Juli 2025. Ein aktives Einreichen der Fortbildungspunkte ist dabei nicht vorgesehen.Ab Juli 2027 wird die Landespflegekammer stichprobenartig Pflegefachpersonen anschreiben und die Nachweise des vergangenen Fortbildungszyklus einfordern. Nach Aufforderung der Landespflegekammer Rheinland-Pfalz kann das Zertifikat gemeinsam mit weiteren Kursinformationen zur Anerkennung der Pflichtpunkte eingereicht werden. Die endgültige Entscheidung über die Anerkennung trifft die Kammer individuell.Die Landespflegekammer Rheinland-Pfalz zertifiziert Bildungsangebote grundsätzlich nicht im Voraus. Wir stehen im Austausch mit der Kammer und gestalten unsere Kurse nach den aktuell vorliegenden Richtlinien, um die Anerkennung mit sehr großer Wahrscheinlichkeit zu ermöglichen – eine Garantie können wir jedoch nicht geben.Weitere Informationen stellt die Landespflegekammer Rheinland-Pfalz auf dieser Webseite zur Verfügung.
Die Online-Fortbildung „Antibiotikatherapie - Vertiefung” ist anerkannt durch die Ärztekammer Nordrhein (bundesweit gültig).
Die Fortbildung wird mit 22 CME-Punkten zertifiziert. Den Teilnehmer:innen werden die CME-Punkte automatisch auf dem jeweils angegebenen Fortbildungspunktekonto gutgeschrieben, nachdem die Online-CME-Fragen erfolgreich (mind. 7 von 10 Fragen korrekt) beantwortet wurden.
Für alle Teilnehmer:innen gilt die allgemeine AMBOSS-Datenschutzerklärung.
Das Selbststudium wird dir nicht auf AMBOSS direkt bereitgestellt, sondern durch die Fortbildungsakademie medixum des Deutschen Ärzteverlags. Du erreichst medixum über folgenden Link: Selbststudium: Fortbildung Hautkrebs-Screening
Wir schalten dir den Zugang zum Selbststudium auf medixum i.d.R. am Montag nach deinem Kurskauf frei. Du erhältst hierfür zwei E-Mails mit den Betreffen:
- Willkommen auf der Lernplattform von AMBOSS“ - Ein neuer Kurs steht auf der Lernplattform von AMBOSS für Sie bereit“
Der Absender lautet learning.medixum@aerzteverlag.de.
Du erreichst das Selbststudium auf medixum über diesen Link: Selbststudium: Fortbildung Hautkrebs-Screening. Du findest den Link auch in den E-Mails, die du bei Freischaltung der Kursinhalte am Montag erhalten hast.Um darauf zugreifen zu können, ist ein Account beim Deutschen Ärzteverlag (“Mein DÄ”) notwendig.
Schaue hier, was auf dich zutrifft:
Du hast noch keinen Account beim Deutschen Ärzteverlag? Registriere dich dort bitte mit derselben E-Mail-Adresse, die du auch beim Kauf des Kurses verwendet hast.Du hast bereits einen Account beim Deutschen Ärzteverlag und die dort hinterlegte E-Mail-Adresse stimmt mit jener vom Kurskauf auf AMBOSS überein?Du kannst dich direkt dort einloggen und mit dem Kurs loslegen.Du hast bereits einen Account beim Deutschen Ärzteverlag, aber die dortige Login-Adresse stimmt nicht mit jener vom Kurskauf auf AMBOSS überein? Melde dich bei unserem Support unter hallo@amboss.com. Wir können deine E-Mail-Adresse entsprechend anpassen.
Du kannst dich beim Deutschen Ärzteverlag über die Nutzergruppe „Sonstiger Leser“ registrieren.
Das Selbststudium ist in 9 Module aufgegliedert. Die Themen umfassen u.a. Prävention, spezifische Krankheitsbilder wie Hautkrebs sowie das gesetzliche Hautkrebs-Screening in Deutschland. Sobald du ein Modul erfolgreich abgeschlossen hast, wird das nächste Modul automatisch freigeschaltet. Die Inhalte werden in abwechslungsreichen Formaten wie Videos, Quizzen und Präsentationen bereitgestellt.Das Selbststudium umfasst 4 Unterrichtseinheiten à 45 Minuten, sprich 3 Stunden insgesamt. Am Ende des Selbststudiums steht eine Lernerfolgskontrolle an, in der du dein erworbenes Wissen prüfen kannst. Bitte absolviere das komplette Selbststudium vor dem Live-Termin!
Du hast zwölf Monate lang Zugriff auf die Inhalte des Selbststudiums.
Nein, der Kauf der Fortbildung beinhaltet kein AMBOSS-Abonnement.
Um ein Modul abzuschließen, müssen alle Folien durchlaufen sein. Es kann manchmal passieren, dass ein Modul dennoch nicht als abgeschlossen erkannt wird. Ist das bei dir der Fall, leere bitte deinen Browser-Cache und starte den Browser neu.Sollte das keine Abhilfe schaffen, kontaktiere gerne den Kundenservice von medixum über kundenservice@medixum.de.
Solltest du weitergehende Fragen zum Selbststudium haben, ist der Kundenservice von medixum dein Ansprechpartner. Du erreichst ihn via E-Mail: kundenservice@medixum.de.
Viele Informationen findest du übrigens bereits hier: medixum FAQ.
Auch im Selbststudium auf medixum gibt es links unten am Bildschirmrand eine spezielle Hilfe-Sektion namens „Hilfe FAQ“.
Das AMBOSS-Support-Team, unterstützt durch Maike Frieben für die Fortbildung Hautkrebs-Screening, ist wie folgt erreichbar:
- Über unser Kontaktformular, WhatsApp oder per E-Mail: hallo@amboss.com- Telefonisch Mo–Fr zwischen 9 und 17 Uhr unter 030 5770 2210- Bei inhaltlichen Fragen stehen auch die Dozierenden in den Live-Webinaren gerne Rede und Antwort.
Deine Zugangsdaten zum Live-Webinar senden wir dir direkt mit der Kaufbestätigung per E-Mail zu. Außerdem erhältst du von uns einige Tage vor dem Live-Webinar eine Erinnerungs-E-Mail, damit du alles rechtzeitig parat hast.
Für unser Webinar nutzen wir das Programm Zoom, das du dir hier herunterladen kannst. Es ist allerdings auch kein Problem, wenn du Zoom nicht herunterladen möchtest. Du kannst dann ganz einfach durch Klick auf den Zoom-Link in der E-Mail am Webinar teilnehmen.
In Ausnahmefällen ist es möglich, den Termin deines Live-Webinars zu wechseln. Bitte kontaktiere uns in solchen Fällen über hallo@amboss.com und wir schauen gemeinsam, was wir für dich tun können.
Ja, du findest die Präsentationen zum Live-Webinar in einem speziellen Download-Portal. Der Zugang zu diesem Download-Portal ist im Buchdeckel des Begleitmaterials hinterlegt. Sobald du das Begleitmaterial also per Post erhalten hast, kannst du dich im Download-Portal anmelden und auf die Präsentationen sowie weitere hilfreiche Ressourcen zugreifen.
Häufig gestellte Fragen zur Fortbildung
Nutzer:innen, die über einen aktiven AMBOSS-Zugang (z.B. Einzel-Abo oder Kliniklizenz) verfügen, können auf die Online-Fortbildung zugreifen, solange ihr AMBOSS-Zugang aktiv ist.
Die Online-Fortbildung ist grundsätzlich für einen Zeitraum von zwei Monaten konzipiert.
Darüber hinaus besteht wie oben genannt die Möglichkeit weiterhin auf die Online-Fortbildung zuzugreifen, solange der AMBOSS-Zugang aktiv ist.
Nutzer:innen ohne aktiven AMBOSS-Zugang (z.B. Einzel-Abo oder Kliniklizenz) erhalten durch den Kauf der Online-Fortbildung einen zweimonatigen Zugriff auf die Fortbildung (inklusive Zugriff auf die AMBOSS-Wissensplattform). Danach besteht die Möglichkeit, einen AMBOSS-Zugang zu erwerben, wodurch auch der Zugriff auf die Online-Fortbildung entsprechend verlängert wird, solange der AMBOSS-Zugang aktiv ist.
Unsere Online-Fortbildungen sind so konzipiert, dass sie auch neben dem ärztlichen Alltag innerhalb von zwei Monaten absolviert werden können. Der Zugriff auf die Kursinhalte besteht auch nach dieser Zeit, solange ein aktiver AMBOSS-Zugang (z.B. Einzel-Abo oder Kliniklizenz) vorhanden ist, um Kursinhalte zu wiederholen oder Inhalte nachzuschlagen.
Diese Fortbildung wurde frei von finanziellen Interessenkonflikten und Sponsoring erstellt und ausschließlich durch die AMBOSS SE ermöglicht. Das Konzeptionsteam der AMBOSS-Online-Fortbildung Antibiotikatherapie - Vertiefung besteht aus:
Prof. Dr. med. Detlef Kindgen-Milles
- Forschungsförderung Fresenius Medical Care, Infectopharm, Diamed
- Vortragstätigkeit: Biotest, Cardiotours, Cytosorbents, Diamed, Fresenius Medical Care, Infectopharm, med update, Orion Pharma
- Beratertätigkeit: Fresenius Medical Care, Diamed, MSD
Prof. Dr. med. Timo Brandenburger
- Deutsche Gesellschaft für Anästhesiologie & Intensivmedizin, Deutsche Interdisziplinäre Vereinigung für Intensiv- und Notfallmedizin, European Society of Intensive Care Medicine & Berufsverband Deutscher Anästhesisten
- Berufliche Stationen u.a. bei Bayer, Biomerieux, Gilead, Fresenius Medical Care, Stadapharm und Grünenthal
Die Online-Fortbildung „Antibiotikatherapie - Vertiefung” ist anerkannt durch die Ärztekammer Nordrhein (bundesweit gültig).
Die Fortbildung wird mit 22 CME-Punkten zertifiziert. Den Teilnehmer:innen werden die CME-Punkte automatisch auf dem jeweils angegebenen Fortbildungspunktekonto gutgeschrieben, nachdem die Online-CME-Fragen erfolgreich (mind. 7 von 10 Fragen korrekt) beantwortet wurden.

.png)





